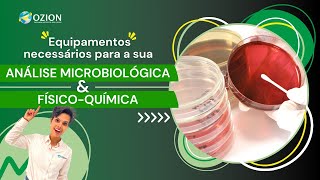

Materiais e equipamentos de laboratório - Brasil Escola
84.12k views3593 WordsCopy TextShare

Brasil Escola Oficial
Na aula de hoje, vamos conhecer os mais variados equipamentos e vidrarias utilizados em um laboratór...
Video Transcript:
[Música] [Aplausos] [Música] fala galerinha beleza Professor chovem na Área hoje nós vamos falar sobre materiais e equipamentos de laboratório então você que nunca foi num laboratório não tem esse contato fica na aulinha de hoje que nós vamos falar aí sobre os equipamentos e materiais mais comuns em um laboratório de química bom antes da gente começar Se você não é inscrito no nosso canal aproveita esse tempinho se inscreva Ativ o Sininho de notificações todo vídeo que a gente for subindo você já vai ficar ligadinho Fechou então pega o seu material que a aula já vai [Música]
começar fala galerinha beleza Professor chovem aqui na área então hoje nós vamos falar sobre materiais e equipamentos de laboratório tá então vou dar uma passada geral em 34 materiais e equipamentos de laboratório que são os mais comuns tá em laboratório de química então fica ligadinho vou tentar ser rápido o mais dinâmico possível para não ser enjoado chato demais a gente ficar só amassando barra aqui beleza então vamos lá então Sem Mais delongas primeiro material que a gente vai estudar equipamento Zinho vidraria muito famosa é o tubo de ensaio Olha o nome tubo de ensaio quando
eu vou ensaiar alguma coisa não é o que tá valendo eu primeiro estou testando então o tubo de ensaio ele é uma vidraria utilizada para que você realize pequenos testes reacionais para que você teste primeiro uma reação em pequena escala para que depois ela seja gerada em larga escala para não dar prejuízo não né gerar riscos e em uma magnitude maior belezinha Tranquilão tubo de ensaio é isso então vai aparecendo sempre a imagenzinha aqui do lado para você dar uma olhadinha na vidraria fechou beleza vamos lá pro segundo segundo que nós vamos ver hoje é
a pinça de madeira e ela tem uma estreita relação com o tubo de ensaio se você notar ela parece um prendedor de roupa só que você tá vendo que em uma das astes ela tem um alongamento essa pinça pessoal ela é utilizada para que você segure o tubo de ensaio e consiga levar ele ao aquecimento sem ter algum risco né de queimadura Então ela é acoplada quando você precisa aquecer algo que está no tubo de ensaio bom terceiro equipamento que nós vamos falar aqui pessoal é a baqueta ou bastão de vidro bom olha o nome
é bem sugestivo né é um bastão de vidro baque inha da bateria só que de vidro para que que ela é utilizada ela é utilizada na dissolução dos sólidos para ajudar ali na dissolução de alguns sólidos e quando você quer manter algo em constante agitamento ali agitação ali mas algo que você não vai ter que ficar agitando muito você vai utilizar a baque tenha manter um líquido né em constante agitação você utiliza a baqueta belezinha quarto equipamento nós chamamos de piceta a piceta pessoal se você observar na imagem ela é um tubo que armazena ali
líquido e ela tem uma cabecinha né que é um pouquinho curvada para que que ela é utilizada ela é utilizada para que você Lave a substâncias ou melhor dizendo Lave as vidrarias e equipamentos sem a necessidade de virar a vidraria então com a piceta como ela tem essa esse biquinho Curvo você consegue lavar a vidraria sem precisar deitar esse esse equipamento Então ela é utilizada para lavar fazer assepsia de vidrarias e equipamentos e você pode utilizar água álcool e até mesmo outros solventes galerinha quinto equipamento quinta vidraria funil comum ou funil simples tá esse funil
ele é utilizado se você observar ele é um funil comum de fato ele é utilizado para que você possa realizar aquele processo de separação de mistura chamado filtração Simples então coloca o funil papel filtro filtra sólido fica no papel líquido desce simples assim agora o sexto equipamento a sexta vidraria na verdade não é de vida ela é de porcelana é o funil de buchner ele é um funil um pouquinho diferente ele é utilizado na filtração a vácuo se você não assistiu a nossa aula de métodos de separação de mistura corre aqui no canal e procura
métodos de separação de mistura tem umas aulas aqui muito completinhos e uma dela você vai ver que eu vou explicar a filtração a vácuo esse funil é o funil específico para filtração a vácuo ele é acoplado em uma vidraria que a gente vai ver hoje que se chama kitassato por meio de uma borracha vedando e é ligado uma bomba de pressão reduzida nesse kitassato e você percebe que esse funil ele é diferente ele é um funil que ele tem uma superficie Zinha toda porosa todo furadinho é para que aconteça uma sucção de ar aí acelere
o processo de filtração então o funil de buchner é o funil que deve ser utilizado na chamada filtração a vácuo que o nome correto é filtração a pressão reduzida pois não é possível criar um vácuo nessas condições Tudo bem então funil de buchner filtração a vácuo bom pessoal já que eu falei do Funil de buchner agora nós vamos para o sétimo equipamento sétimo equipamento é o kitassato kitassato Então pessoal é o que vai ser acoplado aí ao funil de buchner como eu tava explicando tá vendo que ele tem uma boquinha aí lateralmente é onde você
encaixa a mangueira da bomba de pressão reduzida logo acima dessa boca eí superior você encaixa o funil de buchner tudo vedado com papel filtro Então você vai realizar uma filtração reduzida que nada mais é que uma filtração simples em uma velocidade maior belezinha próxima vidraria ou equipamento oitavo equipamento é o funil de decantação ele também pode ser chamado de funil de separação ou funil de bromo para que que ele é utilizado Olha o nome funil de decantação é para você promover o método de separação de misturas chamado decantação de misturas heterogêneas por exemplo um exemplo
que quase ninguém usa água e óleo né colocou água e óleo óleo em cima água embaixo coloca dentro do Funil viu que ele tem uma torneira embaixo abre deixa toda a água descer esc arrotado da água fecha óleo ficou em cima água desceu separei os dois belezinha nono equipamento é o suporte Universal olha só que loucura né suporte universal ele tem uma base metálica com a de metal onde você vai fixar algumas vidrarias algumas vidrarias necessitam de fixação como a bureta né então a gente utiliza o suporte universal para dar essa base de fixação para
outros equipamentos e o décimo equipamento que é o anel ou argola metálica esse que tá aparecendo aqui você viu aí na imagem ele já tá grudadinho aí no suporte Universal Pois é pessoal ele é utilizado como suporte do Funil de decantação eu coloco então suporte Universal prendo o anel argola metálica e encaixo o funil de decantação ali por cima pronto o problema resolvido eu já posso realizar a minha decantação pessoas esse outro equipamento que eu vou mostrar para vocês agora equipamento de número 11 ele é conhecido como garra metálica tá e ele também é acoplado
no suporte Universal fazendo com que algumas estruturas possam ser presas o próximo que é o equipamento de número 12 ele tem um nome engraçado almofariz com pistilo Olha que nome legal né o alaris comp estilo nada mais é que vamos lá tentando deixar bem tranquilo para vocês né fui mostrar essa vidraria um dia pro meu pai tem algumas vidrarias lá em casa ele disse ah meu filho is é amassador de alho pois bem que que a gente faz com amassador de alho a gente não tenta triturar O alho Pois é o almofariz com pistilo ele
é uma vidraria né de porcelana que é utilizada para triturar sólidos no laboratório belezinha então não se esqueça almofariz com pistilo pessoal vou falar agora do 13 e do 14 meio que juntos né Nós temos primeiro 13 que é o vidro de reló relógio tá ele é utilizado em evaporação de soluções e também em pesagens então a vidraria de uso geral e nós temos a cápsula de porcelana essa daí pessoal ela é utilizada na evaporação de soluções então é de maneira específica tá ela uma vidraria mais específica do que o vidro de relógio Mas você
percebe que as duas podem ser utilizadas em evaporações só que o vidro de relógio é uma vidraria mais geral também pode ser utilizado em pesagens pessoal O Cadinho é o um recipiente que é utilizado para aquecimento né muito intenso Então vou submeter ele a um calor muito bruto Então essa vidraria esse equipamento ele é utilizado então para um aquecimento muito intenso inclusive de sólidos tá no forno mufla e em outros outros tipos de aquecimento também como num bico de bunsen que a gente vai ver agorinha O que vem a ser Tá então não se esqueça
dessa vidraria Cadinho aquecimento intenso principalmente de sólidos 16 17 18 ó bico de bunsen nós temos o tripé de metal e o triângulo de porcelana Vamos por partes bico de bumsen é um equipamento que é acoplado em uma mangueira com gás e você consegue produzir uma chama tá então ele é utilizado para aquecimento é uma um equipamento que está em desuso hoje nós temos as mantas né não utilizamos tanto o bico de bunsen por conta do perigo do que ele pode gerar por ser uma combustão Mas ainda é utilizado Tudo bem então bico de munsen
para produzir essa chama produzir calor para que você aqueça alguma alguma vidraria algum alguma substância dentro dessa vidraria algum reagente já o tripé de ferro é para que você coloque a vidraria sob esse tripé de Ferro para que ela não fique em contato né muito próximo do fogo na verdade é um suporte para que seja utilizado junto com o bico de bunsen Bic de bunsen vem aqui tripé de Ferro vem por cima e aí você consegue colocar a sua vidraria ali por cima para se assemelhar ali a um fogareiro né só que olha que detalhe
interessante a próxima vidraria que eu vou comentar agora o equipamento na verdade que é a o triângulo de porcelana sabe para que que ele é utilizado você coloca o Big de bunse coloca o tripé de ferro no tripé de ferro nessa argola que ele tem em cima você vai colocar o triângulo de porcelana e quem que eu coloque em cima do triângulo de porcelana O Cadinho lembra do Cadinho que eu falei que é para aquecimentos a seco mesmo aquela coisa intensa Pois é coloca em cima do triângulo de porcelana ah Professor Então eu só uso
o triângulo de porcelana não a próxima vidraria Na verdade o próximo equipamento que é chamado de tela de amianto também pode ser utilizado sob o tripé de Ferro a tela de amianto ela é utilizada sobre o tripé de ferro e logo acima também na verdade tripé de Ferro acima do Big de bunsen e a tela de amianto acima do tripé para que você coloque a vidraria ali sob a tela de amianto e esse aquecimento aconteça de maneira uniforme na vidraria muita gente imagina que é só colocar ali sob e deixar o bico de buom sem
bater ali no centro mas aí é uma chama um calor localizado a tela de amianto serve para uniformizar esse calor que vai ser fornecido pra minha vidraria que tá sobre todo esse aparato nossa hein não acaba mais não hein vamos vamos lá próxima vidraria é o Becker Cuidado hein Becker O Becker é uma vidraria de uso geral é utilizado para fazer reação é utilizado para fazer dissolução é utilizado para precipitações pode ser aquecido então o Becker ele é uma vidraria de uso geral tá então fica ligado aí no Becker e nós temos a próxima que
é o erlen meer incrivelmente um menino em uma prova M escreveu coloquei a foto da vidraria e perguntei qual é o nome dessa vidraria né o nome dela é erlen meer e pasm né escreveram José meer eu falei tudo bem Pode ser né não tem problema então o herlen meer tá é uma vidraria utilizado num processo chamado de titulação tá titulação lá da físicoquímica pessoal ele também pode ser utilizado para mistura de soluções aquecimento de soluções reações ali mais tranquilas tá então llen meer bastante utilizado ele tem essa esse formato triangular na sua base e
a boca um pouquinho superior facilita ali o manuse para que você consiga agitar sem que passe pela boca sem que saia para fora do recipiente Fechou então erlen meer não é José meer vamos para a próxima bom próxima vidraria próxima vidraria aí a ser estudada é a proveta proveta ela é utilizada para medir e transferir líquidos só que sem uma exatidão Tá eu vou explicar isso agorinha para vocês é uma vidraria interessante vai medir vai aferir um negócio ali massa mas vai ter uma precisão quantitativa aquela coisa ali que eu posso levar pra pesquisa que
aquilo é um dado ali seguro não vidrarias que possuem essa graduação essa escala na vidraria São vidrarias que não possuem precisão vidrarias de precisão elas possuem apenas um traço de aferição apenas um São vidrarias à quais nós chamamos de vidrarias volumétricas elas são vidrarias de precisão tanto é que não podem ser levadas ao aquecimento tem todo um processo ali para que você cuide dessa vidraria e ela te ofereça o o que é prometido tá então proveta medir transferir volumes e nós temos também a pipeta graduada tá vendo pipeta graduada várias graduações a pipeta graduada também
é utilizada para transferir e medir líquidos só que numa quantidade menor pessoal toma bastante cuidado a pipeta é para ser utilizada com a Peira tá de borracha que é outra vidraria que a gente vai falar você acopla uma na outra e vai sugando esse líquido mais ou menos da mesma forma com que você v com Cont gutas tá então toma cuidado com esse detalhezinho então não se esqueça vidrarias que tem graduações várias graduações né que tem ali uma escala muito grande vidraria que não possui uma precisão alta vidraria que tem apenas um traço de aferição
vidraria de alta precisão vidraria volumétrica beleza bom a pipeta volumétrica que é a próxima vidraria que nós vamos ver agora tá vendo o nome pipeta volumétrica essa tem uma exatidão boa tá ela tem apenas um traço de aferição pessoal essa que tá aparecendo aí tá vendo que ela tem uma barriguinha no meio dela pois é essa é utilizada para medir volumes tá de líquidos com exatidão e é um volume fixo Ah eu tenho uma pipeta de 30 ml eu tenho uma pipeta de 40 ml eu tenho uma pipeta de 10 ml pipetas graduadas possuem apenas
uma forma de aferir ali aquela graduação tá então toma cuidado pipeta volumétrica perdão tem só uma Uma um traço de aferição dessa gradação tá então pipeta volumétrica exatidão na sua medida da mesma maneira que a próxima vidraria que eu vou mostrar para vocês agora que é o balão volumétrico o balão volumétrico ele é bastante utilizado no preparo de soluções Ele pessoal ele também possui uma exatidão na sua medida perceba que ele só tem um traço de aferição é utilizada em misturas Soluções em preparo de soluções tá então fica ligado aí vidrarias que t esse volumétrico
costumam ser vidrarias de precisão olha só que legal né Falei da volumetria da precisão só que olha essa vidraria agora a bureta a bureta pessoal a vidraria também utilizada para medir tá líquidos é utilizado num processo chamado de titulação também então ela acoplada no suporte Universal com uma garra metálica logo abaixo o Arlen me ela é uma vidraria que possui várias graduações tá vendo aí na imagem porém ela é de precisão a bureta é uma vidraria de precisão então toma bastante cuidado com isso daí ela é uma exceção Zinha aí ao a regrinha que eu
tava passando para vocês próxima vidraria balão de fundo chato balão de fundo chato pessoal ele é utilizado no preparo de soluções na mistura de soluções que vão desprender gases ou soluções que você precisa aquecer inclusive ele é um balão que pode ser utilizado sob o tripé sob a tela de amanto sob aquec cento do bico de busen Beleza então fica ligado aí no balão de fundo chato bom pessoal nós temos também o balão de destilação o nome é bem sugestivo né um balão que é utilizado no processo de destilação você vai aquecer ali o líquido
a ser destilado a mistura a ser destilada tá outra vidraria também melhor dizendo outro equipamento é a espátula a espátula essa vidraria Zinha aí esse equipamento perdão e Mania esse equipamento Zinho aí éem inox é utilizado para que você consiga manusear sólidos né então às vezes o reagente ele tá ali um pouco empedrado você precisa Então transferir sólido de um lugar pro outro você utiliza a espátula e outra vidraria que eu já vou emendar aqui é o condensador cara o condensador presta bastante atenção tá vendo que ele tem uma parte aí interna que tá E
em forma de espiral e uma parte essa parte que tá em forma de espiral tá dentro de uma espécie de cilindro de vidro é porque aí nessa espiral vai passar de maneira muito lenta o o vapor que tá sendo destilado por fora eu vou ter entrada e saída de água que vai estar resfriando Então esse esse serpentin fazendo com que ele consiga ser condensado e cair separando então um líquido do outro então esse é o condensador ele é utilizado em conjunto por exemplo com o balão de destilação tá vendo aí a relação então condensador utilizado
no processo de destilação vamos lá finalizar graças a Deus vamos finalizar né Quatro últimos vamos vamos lá primeiro dos quatro últimos é chamado de dessecador dessecador é um equipamento é em que você vai produzir um ambiente com baixa umidade Então tá vendo que essa esse sistema de vidro logo abaixo você possui ali um reservatório para que você coloque algum material que consiga absorver a umidade no caso nós podemos utilizar sílica tá então você produz esse ambiente de baixa umidade outro equipamento bastante utilizado é a estufa para que que serve a estufa a estufa pessoal é
um equipamento que é utilizado para secagem tá para calor moderado Eu quero secar alguma coisa Eu quero incidir um calor moderado eu coloco na estufa Em contrapartida nós temos o forno mufla que é para aquecimento bruto mesmo o forno mufla é utilizado para aquecimento intenso inclusive as paredes interiores do Forno mufla são revestidos com uma material refratário para aumentar mais ainda a intensidade de calor dentro desse tipo de forno e para finalizar nós temos a perira de borracha que é utilizada junto com a pipeta para que você consiga puxar os líquidos olha só que interessante
dá uma olhada na imagem e me acompanha tá vendo que ela tem três botões se eu não me engano é um a lá em cima um s no meio e um Ezinho na lateral como é que a gente usa ela a gente aperta o a e esse bulbo solta o ar solta o bulbo o bulbo vai ficar pressurizado como se ele tivesse ali sem ar tá aí eu conecto ela na pipeta coloco no líquido e aperto o s a medida que eu vou apertando o s o bulbo vai abrindo Ou seja a pressão vai sugando
o líquido e o líquido vai subindo parei aí eu paro tiro a mão do s o líquido vai ficar preso dentro da minha PIP pipeta eu vou pro outro recipiente onde eu quero colocar aquele líquido aperto o e o e vai fazer com que o líquido desce da pipeta e às vezes sobra um restinho aí o que que a gente faz aperta o e tá vendo que ele tem um bubinho lateral também aperta o e aperta no bulbin lateral e dá umas bombadinho de líquido que tem lá no final e de fato descer tudo que
estava sendo aferido ali na pipeta UFA terminamos né 30 qu materiais e equipamentos de laboratório que são mais utilizados aí no no laboratório ambiente químico e que vai aparecer nas provas aí para vocês então Pessoal espero que você tenha gostado desculpa é uma aula que eu sei que é grande é cansativa mas necessária tá então faça revisão estude anote Veja a aplicabilidade desses materiais e equipamentos nas separações de misturas e nos outros processos químicos que el utilizam e vamos pro quente para aprender essa parada aí fechou Muito obrigado pela atenção de vocês espero que vocês
tenham gostado se gostaram deixa o like aqui embaixo comenta se tiver alguma dúvida ou sugestão Compartilhe o vídeo com todo mundo agora pra galera aprender como é que funciona ali os materiais de um laboratório e não se esqueça aqui embaixo vai ter um link PR os nossos textos tá falando sobre esse mesmo assunto e dá um pulinho lá nas nossas redes sociais lá também a gente solta dica direto né várias informações importantes para vocês ficarem sempre antenados belezinha eu vou ficando por aqui Muitíssimo obrigado e até a próxima
Related Videos

9:31
Por que o álcool em gel ficou pegajoso? - ...
Brasil Escola Oficial
7,684 views

37:58
Principais Vidrarias e Materiais de Labora...
IBAP Cursos
23,676 views

45:34
Biomedicina/Farmácia/Análises Clínicas - Q...
Camila de Souza
12,393 views

10:40
VIDRARIAS DE LABORATÓRIO
Café com química - Prof Michel
192,906 views
7:07
Equipamentos necessários para análise micr...
Ozion Engenharia Sustentável
3,114 views

9:19
PUTIN não deixou BARATO e Zelensky vai pag...
Prof. JeanGrafia | GabaritaGeo |
3,097 views

14:49
KC 390 E SUPER TUCANO; QUANTO $ ELES REND...
Canal AVGAS
3,430 views

7:01
Vídeo Aula, das Vidrarias de Laboratório d...
Emerson Barbosa Da Silva
26,148 views

14:20
Aula básica de vidrarias de laboratório
Rodrigo Henrique
85,058 views

21:30
As principais vidrarias de laboratório
Universo da Biologia Molecular
10,093 views

11:17
Separação de Misturas Heterogêneas - Brasi...
Brasil Escola Oficial
383,336 views

9:38
Principais Vidrarias e Materiais De Labora...
NutriDiversidade
47,330 views

28:36
Práticas de Laboratório Técnicas de Pesagem
Química com o Prof. Jandinei
20,228 views

15:16
Equipamentos básicos de laboratório
Rodrigo Henrique
3,476 views

7:40
24- Vidrarias de Laboratório HD
Química Kássio Kramer
24,528 views

10:32
Segurança em Laboratórios - Módulo I
Gestão de Resíduos Biológicos e Segurança em Laboratório
21,879 views

13:02
REGRAS BÁSICAS PARA TRABALHAR NUM LABORATÓRIO
Doutor Química
25,395 views

23:54
SEPARAÇÃO DE MISTURAS - TUDO O QUE VOCÊ PR...
Café com química - Prof Michel
588,550 views